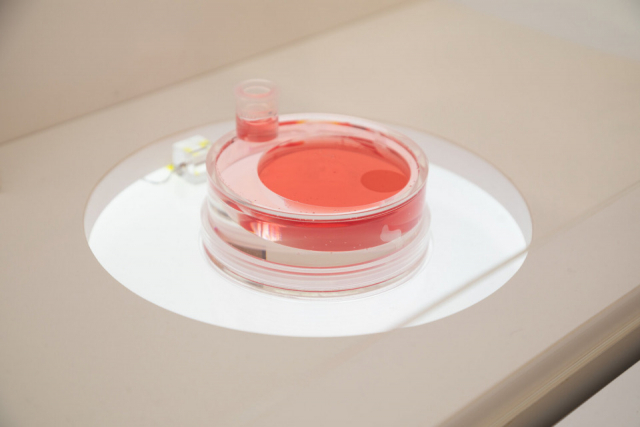
大阪万博の人気パビリオン① 大阪ヘルスケアパビリオン

更新日: 2025年6月7日
大阪万博の人気3パビリオンとイベントをご紹介!話題のガンダムやiPS心臓も!
2025年4月13日に開幕した大阪・関西万博。
抽選予約できるパビリオンの中から、まっぷる編集部がおすすめする人気パビリオンをご紹介します!
158の国と地域が参加し、パビリオンの数はなんと191!
東京ドーム約33個分の敷地を効率よくめぐるために、事前に知っておきたい便利情報も合わせてチェックしましょう。
目次
大阪万博のチケットや予約方法をチェックしよう!
万博来場前の必須事項① 万博IDを登録してチケットを購入
公式チケットサイトにアクセスして、「はじめて購入する」のボタンから万博IDを登録してチケットを購入。家族や友人と来場する場合は、代表者のみ万博IDを取得して、グループ全員のチケットをまとめて管理すると便利!
万博来場前の必須事項② 来場日時を予約
来場する日と時間(9時から1時間きざみ)、入場ゲートを予約。入場ゲートはアクセス方法によって変わるため、事前にアクセス方法を決めておくのがおすすめ。大阪メトロ(地下鉄)、自転車なら東ゲート。駅シャトルバスやパーク&ライド駐車場、水上交通なら西ゲートを予約しましょう!
万博来場前の必須事項③ パビリオンやイベントを予約
来場前に予約できる機会は最大3回(抽選2回、先着1回)。事前予約をしておくと当日は計画的に会場内を周遊できます!当日入場後に会場内に設置してある端末や、スマートフォンで当日予約を行うこともできるため、事前予約がない場合も楽しめるのでご安心を!
入場後の1枠は消化するまで次の予約ができないので、いっぱい見て回りたい!という人は、事前予約を遅めの時間、当日枠は入場すぐの時間にするのがポイント。
●来場1か月前から8日前まで…抽選2回目(最大1枠)/当落発表は7日前から順次
●来場3日前から前日午前9時まで…空枠先着(1枠)
※入場後にも1枠予約可能、入館後、次のパビリオンの予約が可能になります
![]()
万博来場前の必須事項④ 当日に必要なQRを準備
当日は、入場ゲートや各パビリオン・イベントなどで、QRコードをかざして入場。不安な人は紙に印刷やスクリーンショットで保存してもOK。記念チケットを別で申し込むと、QRコードが印刷されたチケットが届きます。
大阪万博の会場の構成をざっくりご紹介
国内パビリオン
開催国である日本、開催地である大阪・関西が手掛ける4つのパビリオン。趣向を凝らした大がかりな展示や体験を提供し、会場を盛り上げます。
民間パビリオン
国内のさまざまな企業や団体が、培ってきたオリジナルの技術や独自の視点から創り上げる民間パビリオン。興味深い世界が広がるパビリオンをのぞいてみましょう!
シグネチャーパビリオン
ロボット工学者や音楽家など、各界の最前線で活躍する8人のプロデューサーが主導する創造的なパビリオン。それぞれが「いのち」について考える場所となっています。
海外パビリオン
160を超える国・地域・国際機関のパビリオンが勢ぞろい。「いのちを救う(セービング)」、「いのちに力を与える(エンパワーリング)」、「いのちをつなぐ(コネクティング)」の3つのサブテーマに分けて配置されます。
万博会場の入り口はこの2か所!
東ゲート
夢洲駅から来場する場合の最寄入場ゲート
西ゲート
駅シャトルバスや、車で来場する際に駐車場からシャトルバスを利用する場合の最寄入場ゲート
万博会場での注目ポイントは「大屋根リング」
屋上から会場全体をさまざまな場所から見渡せる
全長約2km、高さは、内側約12m(外側約20m)、内径約615mの世界最大の木造建築。日本の神社仏閣などの建築に使用されてきた伝統的な貫(ぬき)接合に、現代の工法を加えて建築されています。
大阪万博の人気パビリオン① 大阪ヘルスケアパビリオン
オール大阪の知恵とアイデアが結集した未来の都市へ
大阪府・市や大学・企業などが連携して出展。「REBORN」をテーマに「いのち」や「健康」の観点から、ヘルスケア、エンターテインメント、食文化まで、ミライの大阪の可能性を感じることができる展示体験を提供。多数のイベントも開催予定です。「宇宙シャワー」や「パーソナルフードスタンド」「アイケアステーション」などさまざまな体験ができる点も魅力。
●所要時間…60分
![]()

健康データをもとに生成した25年後の自分(アバター)とミライを体験する「リボーン体験ルート」では、さまざまな測定結果から髪・肌・視覚・脳・歯・筋骨格・心血管のランクが割り出され、カラダ測定年齢が算出される

「リボーン体験ルート」は事前に専用のアプリをダウンロードしておこう。測定結果が体験後にアプリから確認することができる
1階のアトリウム中央にはiPS細胞から作られた心筋シートが展示されている

ミライ人間洗濯機は一般来場者も体験可能だが予約が必要

森永乳業のブースでは、最新技術を使ったゲームでビフィズス菌の効果を体感することができる

ミライの食と文化の魅力を世界に発信する「学び」のデモキッチンエリアと「体験」のフード・物販エリアで構成。画像は「QBBこれもいいキッチン」のグルテンフリーの揚げないドーナツ「ドーナチー」

建物は鳥などの巣がモチーフ。内部は鳥の卵をイメージした楕円形の空間で構成
大阪万博の人気パビリオン② GUNDAM NEXT FUTURE PAVILION
実物大ガンダムがオリジナルポーズで登場
臨場感のある完全新規映像と、フェーズ0から7までのパビリオン空間を通して、ガンダムシリーズが描いてきた世界を体験。宇宙体験後に、再び向き合う実物大ガンダム像に、感慨もひとしお。
●所要時間…50分
![]()

大型スクリーンと振動システムで“新たな宇宙世紀”を全身で感じる大迫力の没入体験

「夢洲ターミナル」から軌道エレベーターで宇宙ステーション「スタージャブロー」まで移動
ガンダムパビリオンの動画もチェックしよう!
ガンダムパビリオンは事前予約に外れても当日予約にチャレンジ
完全予約制のパビリオンではありますが、事前予約に全部外れてしまっても当日予約があるのでぜひ挑戦してみてください。当日予約の開放時間は12:00~、15:00~、17:00~となっているので、遅めにパークインした人でもチャンスはあります。(4月16日現在の情報です)
大阪万博の人気パビリオン③ PASONA NATUREVERSE
iPS 心臓や生命の進化をアトムとブラック・ジャックが紹介
鉄腕アトムがパビリオン全体を、ブラック・ジャックが“からだ(未来の医療)”の展示エリアをナビゲート。心臓を作り上げるiPS心筋シートなど、展示される最新テクノロジーは驚きの連続。からだゾーンには、未来の眠りを体験できるベッドやリモート操作による空飛ぶ手術室などが展示されているので、いろいろ体験してみよう!
●所要時間…30分
![]()

澤芳樹氏が開発する『iPS心臓』を展示している

いのちの歴史、からだ、こころ・きずな、未来の「食」の4つのゾーンにわかれている

“いのちの象徴”としてアンモナイトの螺旋形状を採用
大阪万博で必見のイベント「アオと夜の虹のパレード」
「ウォータープラザ」で行われる、水と空気、光、炎、映像、音楽が織りなす水上ショー。虹がかかる月夜に、生きものたちによる祝祭が開かれるという言い伝えが残る島を舞台に生命の物語が展開されます。
●時間…日没後に開催
●予約…要予約(所要時間約20分)
大阪万博でしか出会えない感動体験をぜひ体感しに行こう!
184日間開催される大阪万博。長いようで、きっとあっという間でしょうね。世界各国から人々が訪れ、多様な文化に触れられるせっかくの機会なのでぜひ訪れてみましょう。
うっかり春の期間を逃してしまうと暑い夏がやってきます。体力を消耗しやすい時期になりますので、午後からは大屋根リングで影の部分が多くなる西側のゾーンをめぐるなど、事前に有益な情報をキャッチしてから行ってくださいね。まっぷるウェブやまっぷるSNSでも、万博に関する便利な情報を随時発信していくので、ぜひチェックしてみてください!
大阪の新着記事
※掲載の情報は取材時点のものです。お出かけの際は事前に最新の情報をご確認ください。

まっぷるトラベルガイド編集部は、旅やおでかけが大好きな人間が集まっています。
皆様に旅やおでかけの楽しさ、その土地ならではの魅力をお伝えすることを目標に、スタッフ自らの体験や、旅のプロ・専門家への取材をもとにしたおすすめスポットや旅行プラン、旅行の予備知識など信頼できる情報を発信してまいります!














